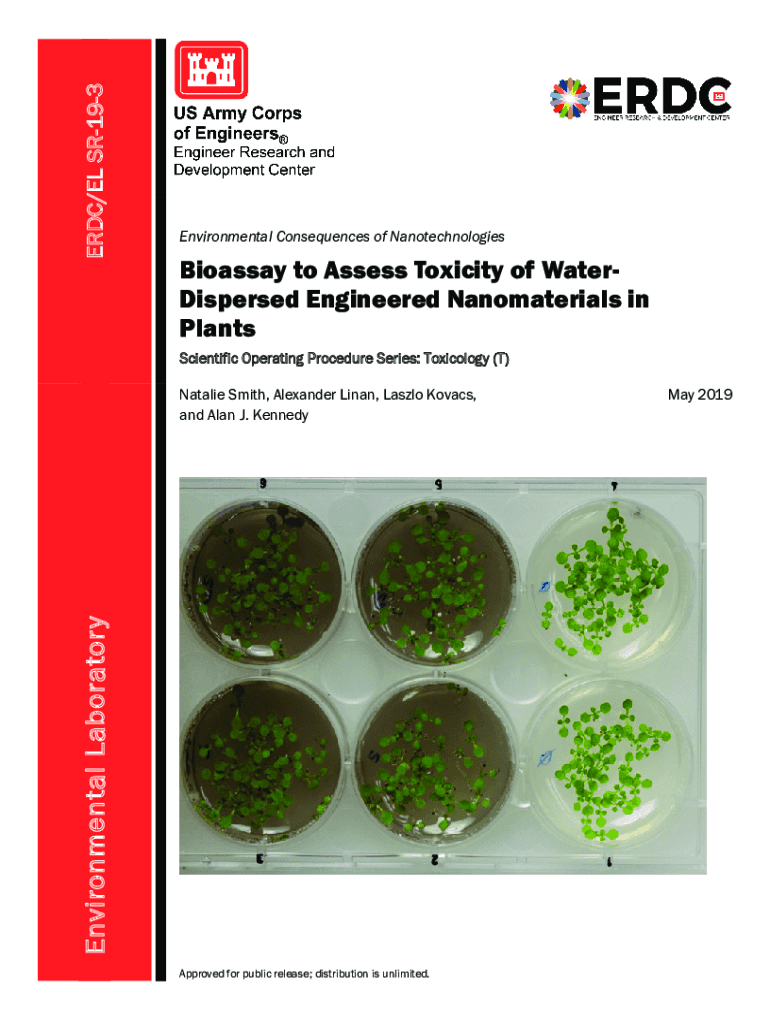

Get the free ERDC/EL SR-19-3 "Bioassay to Assess Toxicity of Water-Dispersed Engineered ...
Show details
ERIC/EL SR193Environmental Consequences of NanotechnologiesBioassay to Assess Toxicity of WaterDispersed Engineered Nanomaterials in Plants Scientific Operating Procedure Series: Toxicology (T)Environmental
We are not affiliated with any brand or entity on this form
Get, Create, Make and Sign erdcel sr-19-3 ampquotbioassay to

Edit your erdcel sr-19-3 ampquotbioassay to form online
Type text, complete fillable fields, insert images, highlight or blackout data for discretion, add comments, and more.

Add your legally-binding signature
Draw or type your signature, upload a signature image, or capture it with your digital camera.

Share your form instantly
Email, fax, or share your erdcel sr-19-3 ampquotbioassay to form via URL. You can also download, print, or export forms to your preferred cloud storage service.
How to edit erdcel sr-19-3 ampquotbioassay to online
Use the instructions below to start using our professional PDF editor:
1
Log in. Click Start Free Trial and create a profile if necessary.
2
Upload a document. Select Add New on your Dashboard and transfer a file into the system in one of the following ways: by uploading it from your device or importing from the cloud, web, or internal mail. Then, click Start editing.
3
Edit erdcel sr-19-3 ampquotbioassay to. Add and replace text, insert new objects, rearrange pages, add watermarks and page numbers, and more. Click Done when you are finished editing and go to the Documents tab to merge, split, lock or unlock the file.
4
Get your file. Select your file from the documents list and pick your export method. You may save it as a PDF, email it, or upload it to the cloud.
With pdfFiller, it's always easy to work with documents. Try it out!
Uncompromising security for your PDF editing and eSignature needs
Your private information is safe with pdfFiller. We employ end-to-end encryption, secure cloud storage, and advanced access control to protect your documents and maintain regulatory compliance.
How to fill out erdcel sr-19-3 ampquotbioassay to

How to fill out erdcel sr-19-3 ampquotbioassay to
01
Obtain a copy of the erdcel sr-19-3 ampquotbioassay form.
02
Fill out the patient's personal information including name, date of birth, and medical history.
03
Provide details of the specific bioassay being performed, including the type of sample collected and the reason for the test.
04
Record any relevant medication or allergies that the patient may have.
05
Sign and date the form to certify its completion.
Who needs erdcel sr-19-3 ampquotbioassay to?
01
Individuals undergoing bioassay testing.
02
Medical professionals performing bioassays on patients.
03
Laboratories handling bioassay samples.
Fill
form
: Try Risk Free
For pdfFiller’s FAQs
Below is a list of the most common customer questions. If you can’t find an answer to your question, please don’t hesitate to reach out to us.
How can I manage my erdcel sr-19-3 ampquotbioassay to directly from Gmail?
erdcel sr-19-3 ampquotbioassay to and other documents can be changed, filled out, and signed right in your Gmail inbox. You can use pdfFiller's add-on to do this, as well as other things. When you go to Google Workspace, you can find pdfFiller for Gmail. You should use the time you spend dealing with your documents and eSignatures for more important things, like going to the gym or going to the dentist.
How can I edit erdcel sr-19-3 ampquotbioassay to on a smartphone?
The pdfFiller mobile applications for iOS and Android are the easiest way to edit documents on the go. You may get them from the Apple Store and Google Play. More info about the applications here. Install and log in to edit erdcel sr-19-3 ampquotbioassay to.
How do I complete erdcel sr-19-3 ampquotbioassay to on an Android device?
Use the pdfFiller Android app to finish your erdcel sr-19-3 ampquotbioassay to and other documents on your Android phone. The app has all the features you need to manage your documents, like editing content, eSigning, annotating, sharing files, and more. At any time, as long as there is an internet connection.
What is erdcel sr-19-3 ampquotbioassay to?
Erdcel sr-19-3 ampquotbioassay is a form used to report bioassay results.
Who is required to file erdcel sr-19-3 ampquotbioassay to?
Employees working with radioactive materials are typically required to file erdcel sr-19-3 ampquotbioassay.
How to fill out erdcel sr-19-3 ampquotbioassay to?
To fill out erdcel sr-19-3 ampquotbioassay, one must provide relevant bioassay results and information as requested on the form.
What is the purpose of erdcel sr-19-3 ampquotbioassay to?
The purpose of erdcel sr-19-3 ampquotbioassay is to monitor and track radiation exposure for individuals working with radioactive materials.
What information must be reported on erdcel sr-19-3 ampquotbioassay to?
Information such as bioassay results, radiation exposure levels, and personal details of the individual must be reported on erdcel sr-19-3 ampquotbioassay.
Fill out your erdcel sr-19-3 ampquotbioassay to online with pdfFiller!
pdfFiller is an end-to-end solution for managing, creating, and editing documents and forms in the cloud. Save time and hassle by preparing your tax forms online.
Erdcel Sr-19-3 Ampquotbioassay To is not the form you're looking for?Search for another form here.
Relevant keywords
Related Forms
If you believe that this page should be taken down, please follow our DMCA take down process
here
.
This form may include fields for payment information. Data entered in these fields is not covered by PCI DSS compliance.